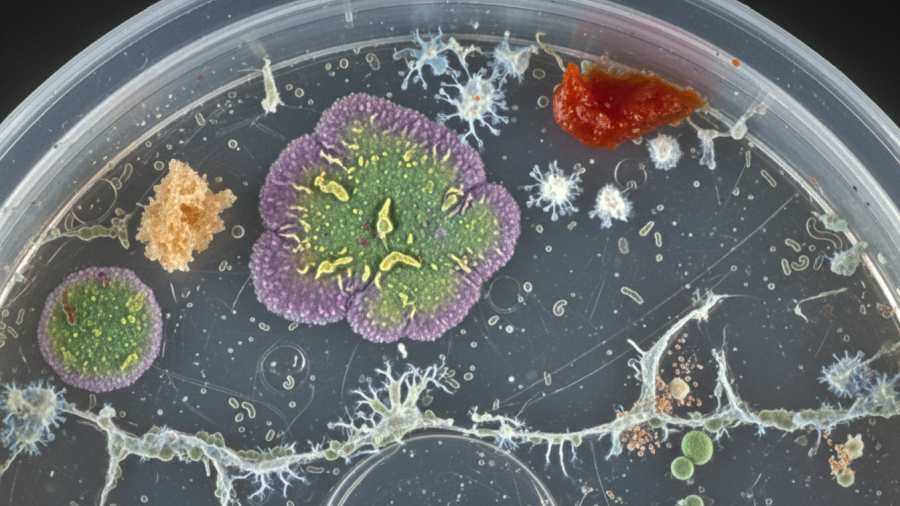
Eco-friendly jelly ice cubes promote sustainable ice options for water conservation.

Sustainable living is often cheaper than people expect because many of the most effective eco-friendly habits involve using less, wasting less, and making better use of what you already have. The common belief that living sustainably requires expensive products or major home upgrades overlooks the fact that simple choices—such as reducing energy use, cutting food waste, reusing everyday items, and conserving water—can lower household expenses while also reducing environmental impact. Imagine it’s a bright morning in your sunlit kitchen. You’re sipping coffee, sorting the recyclables with your family, and noticing something remarkable: these small, thoughtful actions not only feel good—they’re saving you money over time.It's a moment many people overlook, yet it reflects an important reality: sustainable living is often less about spending more money and more about making thoughtful everyday choices. Those choices may seem small, but they can reduce waste, conserve resources, and help households save money over time.Everyday Choices: Sustainable Living Starts at HomeSustainable living is not just for wealthy people or those with lots of free time. It starts with the everyday choices people make at home. Simple actions like turning off lights, using reusable containers, or composting food scraps may seem small, but they can make a real difference over time.Many people believe that living a greener lifestyle means spending a lot of money on special products or expensive home upgrades. In reality, simple habits like saving water, reducing waste, or changing how you travel can help the environment and may even lower household costs over time. According to Katherine Milkman, a professor at the Wharton School of the University of Pennsylvania and author of How to Change: The Science of Getting From Where You Are to Where You Want to Be, lasting change usually comes from small actions repeated over and over rather than major lifestyle changes. Her research shows that people are more likely to stick with habits when they are easy, convenient, and fit naturally into daily life. When it comes to sustainable living, that could mean bringing reusable shopping bags to the store, wasting less food, or turning off electronics when they are not being used. These simple habits can have a bigger long-term effect than expensive purchases because they become part of a person's routine. Think about how everyday habits affect the world around us. Turning off unused electronics, recycling correctly, and growing herbs in a windowsill garden can help reduce waste and may even lower utility bills. The idea behind Why Sustainable Living Doesn't Have to Be Expensive is simple: many environmentally friendly choices come from using resources wisely and avoiding unnecessary waste. Many sustainable habits cost little or nothing to start. They often focus on getting more value from what you already have. As more families make these choices, communities can also benefit by supporting practical and affordable solutions instead of costly upgrades.Small steps that make a big differenceCommon myths about the cost of sustainable livingHow everyday habits shape environmental outcomes What You'll Learn About Why Sustainable Living Doesn't Have to Be ExpensiveRecognize simple, low-cost sustainable alternativesLearn how individual decisions impact the environmentUnderstand community and policy roles in supporting affordable sustainabilityExpanding the View: Why Everyday Actions MatterEvery action at home—from turning off a light to bringing a reusable bag to the store—can affect more than just your monthly bills. These everyday choices also influence how much energy, water, and other resources we use, which can have an impact on the environment over time. When people take a closer look at their daily habits, they often find simple ways to make positive changes. These changes can help save money, reduce waste, and support a healthier environment. That's one reason why sustainable living doesn't have to be expensive—many improvements start with small actions that fit naturally into everyday life. When these habits become part of a normal routine, they are easier to maintain. For example, unplugging electronics before leaving home may seem like a small step, but over time it can reduce energy use, lower utility bills, and help cut down on unnecessary emissions. Sustainability often grows through small choices made day after day. While a single action may seem minor, many people making simple changes over time can create meaningful progress for both their communities and the environment.Exploring the Resource Impact of Daily Choices The way we use energy, water, and everyday products affects the resources available for everyone. In many homes, saving energy can start with simple changes like switching to LED light bulbs, adjusting the thermostat when needed, or making better use of natural sunlight during the day.Small habits can also make a difference over time. Using less electricity when possible, unplugging devices that are not being used, or letting clothes air-dry instead of using a dryer can help lower energy use and reduce utility bills.Water is another area where everyday choices matter. Fixing a leaking faucet, running the dishwasher only when it is full, or collecting rainwater for outdoor plants can help reduce water waste and place less demand on local water supplies.People can also reduce waste by choosing reusable products instead of disposable ones, repairing items that still work, and buying secondhand when possible. These habits help people get more use from the things they already have while reducing the amount of waste sent to landfills.When millions of households make small changes like these, the results can add up. Together, these everyday actions can help protect natural resources, reduce waste, and save money without requiring expensive purchases or major lifestyle changes.Energy consumption and conservation at homePlastic and water use—making wise decisions Sandra Postel, founder of the Global Water Policy Project, has spent many years studying how people and communities use and protect water resources. She was recognized by Scientific American as one of its Visionaries of the 20th Century for her contributions to environmental science. Throughout her career, Postel has highlighted an important idea: conserving water is often one of the most affordable and effective ways to protect water supplies. Her work shows that simple actions at home can make a difference. Saving water can help protect local water resources, support long-term water availability, and lower monthly utility bills without requiring expensive upgrades or major investments.Setting the Record Straight: Is Sustainable Living Really Costlier?Many people believe that living sustainably costs a lot of money. But that isn't always the case. The key is understanding the difference between paying a little more upfront and saving money over time. For example, a reusable water bottle or LED light bulb may cost more than a disposable bottle or traditional bulb at first. However, because they last longer and can be used again and again, they often save money in the long run. In many cases, creating less waste also means spending less money on replacements and everyday purchases.Many households say they have reduced their expenses by composting food scraps, buying secondhand items, wasting less, or using public transportation when it is available. The amount of money saved will be different for every household. Even so, these choices can help lower ongoing expenses while also reducing environmental impact. Over time, a series of small changes can add up to meaningful savings and positive benefits for the environment.Research and Real-Life ExamplesResearchers and consumer groups have found that many sustainable habits can save money over time. Using energy-efficient light bulbs, wasting less food, growing some food at home, sealing drafts around doors and windows, and choosing alternatives to driving can often be done with little upfront cost. These changes can lead to ongoing savings through lower utility bills, reduced fuel costs, and fewer purchases over time. Many families in these studies reported spending less money as they reduced waste and became more efficient with the resources they already had. Instead of focusing on buying new products, many sustainable approaches encourage people to get more value from what they already own by repairing, reusing, and making better use of everyday items. Real-life examples show how small changes can add up. Households that use fewer disposable products, switch to reusable alternatives, or focus on reducing food waste often report spending less on replacement items and other regular purchases. Although results differ from one household to another, these experiences support a common finding in sustainability research: when people create less waste, they often spend less money as well.Comparing upfront vs. long-term costs for common sustainable practicesStories from individuals and families who have saved money Table: Comparing Traditional vs. Sustainable Daily PracticesCategoryConventional ApproachSustainable AlternativeShort-term CostLong-term SavingsEnergy usageIncandescent bulbs, always-on devicesLED bulbs, unplugging devicesSlightly higher upfront (bulbs)Lower utility bills over timeWaste disposalSingle-use plastics, mixed trashComposting, recycling, reusablesMinimal; small investment in binsLess waste, lower replacement costsShopping choicesFrequent buying of disposablesBulk purchasing, secondhand, reusablesPotential savings upfrontPotential savings over timeTransportationSolo car rides, short trips by carBiking, carpooling, public transitLimited—bike or pass purchaseReduced fuel/maintenance expensesCommunity Innovations: Affordable Sustainability in ActionSustainable living is often easier when communities work together. Across neighborhoods, towns, and cities, people are creating practical ways to make environmentally friendly choices more affordable and accessible. Community gardens, food co-ops, tool libraries, and repair cafés are good examples. These programs show how people can share resources, help one another, and make sustainable living easier without spending a lot of money. Many of these programs are built around sharing and cooperation. By sharing tools, growing food together, or repairing items instead of replacing them, communities can help reduce costs and waste while making everyday life more affordable. Local partnerships and community-led projects also play an important role. Tool-sharing programs, community compost sites, and other neighborhood efforts help people get more value from existing resources instead of buying new ones. In many cases, the solution is not purchasing more things but finding better ways to share and use what is already available. A neighbor growing vegetables in a shared garden or a library hosting a clothing swap may seem like small examples, but they can inspire others to make similar changes. These local efforts often show that sustainable living and affordability can work hand in hand. Environmental advocate Annie Leonard is best known for creating The Story of Stuff, a widely viewed educational project that explores consumer habits, waste, and the use of natural resources. Through many years of research and public education, Leonard has explained that many environmental problems are caused not by a lack of resources but by buying, using, and throwing away more than necessary. Her work supports the idea that repairing, reusing, sharing, and keeping products in use longer can help reduce both household expenses and environmental impact. Tool libraries, repair cafés, clothing swaps, and secondhand marketplaces put this idea into practice. They help people get access to the items they need without constantly purchasing new products, saving money while reducing waste.How Local Initiatives Make Sustainable Living AccessibleCommunity gardens give people a chance to grow some of their own food without spending a lot of money. They also help residents spend time outdoors, connect with nature, and reduce some of the transportation involved in bringing food from farms to grocery stores. Tool libraries allow people to borrow tools, equipment, and other items they may only need once in a while. This can help households save money by avoiding purchases they may rarely use. Repair cafés support these efforts by teaching practical skills that help people fix, maintain, and continue using everyday items instead of replacing them. Even if someone cannot afford expensive environmentally friendly technology, they can still take part in sustainable living through shared resources, community programs, and learning new skills from others. Partnerships between local governments, nonprofits, schools, and businesses help many of these programs succeed. When organizations work together, they can reach more people, share resources, and create programs that are affordable and open to a wider range of residents. Many community projects begin with local residents who care about making a difference. Their ideas and efforts often inspire new programs that show sustainable living can be practical, affordable, and available to people from all walks of life.Community gardens, lending libraries, repair cafesProgram partnerships and grassroots movements Larger Perspective: Systemic Shifts and Cultural ChangeIndividual actions and community programs can make a difference, but larger changes also help make sustainable living more affordable. Government policies, new technology, and changing public attitudes all play a role in making environmentally friendly choices easier and more accessible.When governments offer rebates for home improvements, support public transportation, or provide financial assistance for energy-saving upgrades, they help more people take part in sustainable living. These programs can make environmentally friendly options available to households that may not be able to afford large upfront costs on their own. Technology is helping as well. Community solar programs, affordable home energy monitors, and convenient recycling services can lower costs and make sustainable choices easier for entire neighborhoods. As communities invest in systems that support sustainability, environmentally friendly living becomes easier for more people. Over time, sustainability can grow from a personal choice into a shared community value supported by programs, services, and infrastructure that encourage wider participation.Policy Support and Innovations That Lower CostsGovernment programs can help make environmentally friendly upgrades more affordable for many families. Rebates for energy-efficient appliances, discounts for home energy improvements, and financial assistance for renewable energy projects can reduce the cost of making sustainable changes at home.Many of these programs are created with input from local communities, advocacy groups, and public leaders. Their goal is to help more households access sustainable options, including those that may not have the money for larger upfront investments. Policies that focus on fairness, accessibility, and community participation help make sustainable living a realistic option for more people. This helps ensure that environmentally friendly choices are not limited to a small group but are available to households from many different backgrounds. Technology is also making sustainable living easier and more affordable. Products and services such as LED lighting, public transportation, and electric bikes are now more available and practical for many consumers than they were in the past. As these technologies become more common, their costs often decrease, making them available to even more people. The bigger lesson is that affordable sustainable living is becoming increasingly possible as communities, technology, and public programs continue to work together.Government incentives and subsidiesTechnological advancements that democratize green living People Also Ask: Exploring Questions Around Why Sustainable Living Doesn't Have to Be ExpensiveDoes sustainable living save money?In many cases, sustainable living can reduce long-term expenses. Practices such as lowering energy consumption, reducing waste, repairing items instead of replacing them, and choosing reusable products often lead to lower household costs over time.While some environmentally friendly products may require an initial investment, the long-term savings frequently outweigh the upfront expense.Why do people think sustainable living is expensive?Many people associate sustainable living with expensive products such as solar panels, electric vehicles, or major home renovations.While those options can involve significant upfront costs, many sustainable practices require little or no financial investment. Actions such as reducing food waste, conserving energy, repairing usable items, purchasing secondhand goods, and choosing reusable products often cost less than their conventional alternatives over time.The perception that sustainability is always expensive frequently comes from focusing on large investments rather than everyday habits.What are some of the cheapest ways to live more sustainably?Some of the most affordable sustainable habits cost little or nothing to implement.Turning off unused lights, fixing household leaks, using reusable shopping bags, reducing food waste, composting kitchen scraps, purchasing secondhand items, and walking or biking for short trips can all reduce environmental impact while helping lower everyday expenses.Many people find that behavioral changes provide greater savings than purchasing new products.Can sustainable living work for renters?Yes. Many of the most effective sustainable habits require little or no financial investment and do not require home ownership.Reducing energy use, minimizing food waste, choosing reusable products, participating in community recycling programs, and supporting local transportation options are practical ways renters can live more sustainably while keeping costs low.Portable options such as reusable containers, LED bulbs, and small herb gardens allow renters to participate in sustainable living without making permanent changes to their homes.Key Takeaways on Why Sustainable Living Doesn't Have to Be ExpensiveAffordable sustainability is realistic and attainable.Small choices amplify into significant collective impact.Community and policy frameworks are key to accessibility. FAQs: Practical Answers for Everyday Sustainable LivingHow can renters practice affordable sustainable living?Renters can take steps like conserving energy, choosing reusable products, supporting local markets, and participating in community recycling programs. Portable solutions—including water-saving showerheads and window herb gardens—require little investment and can move with you.Are all green products more expensive?Not necessarily. Many eco-friendly products, such as reusable containers, cloth bags, or LED bulbs, cost a bit more upfront but provide savings through repeated use. Focusing on behavior and mindful consumption often yields the biggest savings—no purchase required.Where to find local sustainability resources?Start by searching community centers, local government websites, neighborhood social media groups, or nearby libraries. Many cities now offer recycling guides, tool-sharing cooperatives, and shared garden plots to help residents integrate affordable sustainability into daily life.Embracing Change: The Power of Individual and Collective Sustainable ChoicesEvery choice—no matter how small—contributes to a broader movement. By embracing change, whether through mindful consumption or community involvement, we create a future where sustainable living is affordable and accessible for all.Progress isn’t about overnight perfection, but the positive impact of informed, conscious choices made one day at a time.If you're looking for a few simple ideas to reduce waste and save money, this short video offers a helpful starting point. It shares practical, budget-friendly ways to make everyday habits a little more sustainable, proving that living greener doesn't always require a big investment or major lifestyle changes.ConclusionWhether at home, in community spaces, or through policy changes, sustainable living is within reach for everyone. By shifting habits, supporting innovations, and embracing an awareness of resource impact, we make a positive difference—one actionable step at a time.If you're inspired to continue your journey toward a more sustainable and affordable lifestyle, remember that lasting change often begins with small, consistent choices. Whether it's reducing household waste, conserving energy, supporting local sustainability programs, or simply becoming more mindful of everyday consumption, each step can create meaningful benefits over time. Sustainable living is not about perfection or spending more money—it's about making thoughtful decisions that support both personal well-being and the health of the communities and environments we depend on.Explore practical ways to live more sustainably and reduce your environmental footprint through Eco Living, or discover more wellness, lifestyle, and community stories on Sacramento Living Well.---Authored by the Sacramento Living Well Editorial Team — a publication of DSA Digital Media, dedicated to highlighting wellness, local living, and inspiring community stories throughout Greater Sacramento.

Write A Comment